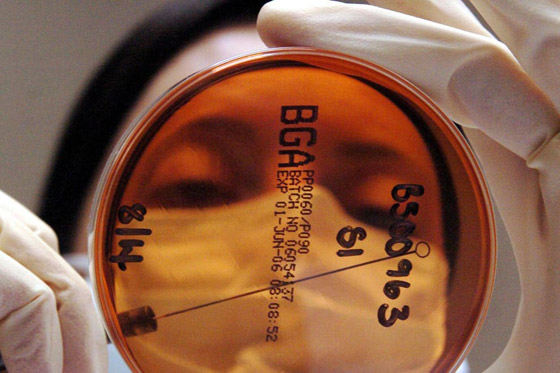
علماء يكتشفون فيروسا جديدا مفيدا للإنسان! يساهم بمكافحة عدوى البكتيريا صورة رقم 4

قد يظن المرء أن الفيروسات شر مطلق، ولا تشكل إلا الخطر على الصحة. وبمجرد أن يسمع الناس عن فيروس جديد ينتابهم الخوف والهلع. إلا أنه في الآونة الأخيرة اكتشف علماء فيروساً قد يكون مفيداً للصحة في بلدة كولني التابعة لمنطقة نورفولك شرق إنجلترا، وفق صحيفة بريطانية.
وفي التفاصيل يدخل هذا الفيروس الذي أطلق عليه اسم البلدة، في الصنف الذي يعرف علمياً بالعاثيات، أي الفيروسات التي تقوم بأكل البكتيريا. كما يرجح الباحثون من معهد "كوادرام" أن يكون هذا الفيروس مفيداً في مقاومة عدوى تصيب أمعاء الإنسان وتسبب اضطرابات مثل الإسهال، من جراء استخدام مضادات حيوية.

يشار إلى أنه جرى اكتشاف هذا الفيروس لأول مرة من قبل باحثين في معهد بحوث الغذاء بمدينة نرويش البريطانية. ويجري الرهان على اكتشاف هذا الفيروس حتى يكون جزءاً من معركة العلاجات ضد بكتيريا الأمعاء، التي تعرف في أوساط الباحثين بـ"المطثية العسيرة".
إلى ذلك توصل الباحثون عند دراسة الفيروس أنه مختلف بما يكفي حتى يجري تصنيفه بمثابة عاثية جديدة، أي فيروس يأكل البكتيريا. ووفق البيانات الطبية، يجري رصد المرض الذي ينجم عن المطثية العسيرة بصورة أكبر لدى البالغين الأكبر سناً في المستشفيات أو في مرافق الرعاية طويلة الأجل، وغالباً ما يحصل هذا الاضطراب الصحي بعد استخدام المضادات الحيوية.

غير أنه رغم ذلك، نبهت بعض الدراسات إلى زيادة معدلات الإصابة بعدوى المطثية العسيرة بين الأشخاص الذين لا يندرجون ضمن الأشخاص الأكثر عرضة للخطر، من قبيل الأصحاء الأصغر عمراً الذين لم يستخدموا المضادات الحيوية أو لم يقضوا فترات طويلة في منشآت علاج.
فقد اكتشف علماء بريطانيون فيروساً جديداً يمكن أن يكون مفيداً للإنسان، في مكافحة عدوى المطثية العسيرة، والمعروفة أيضاً باسم C. difficile أو C. diff، وذلك طبقاً لما أوردته شبكة بريطانية، الخميس. حيث قال علماء يعملون بمعهد أبحاث الغذاء في بلدة كولني، بمقاطعة نورفولك البريطانية، إن فيروس كولني يمكن أن يعالج عدوى المطثية العسيرة التي تهدد الحياة، والتي تتسبَّب في الإسهال والحمى.

هذا الاسم أُطلِقَ على الفيروس الجديد نسبةً إلى اسم القرية التي اكتُشِفَ فيها في مقاطعة نورفولك، التي تقع بشرق إنجلترا في المنطقة الشهيرة بـ"إيست أنجليا". من المأمول أن يشكِّل فيروس كولني جزءاً من علاجاتٍ لمكافحة التهاب المطثية العسيرة، بعد إجراء مزيدٍ من البحث.
والمطثية العسيرة هي بكتيريا يمكن أن تُسبب أعراضاً تتراوح بين الإسهال والتهاب القولون المهدد للحياة، ويؤثر المرض الناجم عنها بصورةٍ أكثر شيوعاً، على البالغين الأكبر سناً في المستشفيات أو بمرافق الرعاية طويلة الأجل، وعادةً ما يحدث بعد استخدام أدوية المضادات الحيوية.
وذلك لأن بكتيريا المطثية العسيرة تصيب الأمعاء، بالأغلب في أثناء تناول المضادات الحيوية، وفقاً للباحثين بمعهد كوادرام للأبحاث الصحية البريطاني (Quadram). أما فيروس كولني، فهو نوعٌ من الفيروسات التي تصيب البكتيريا، ويُعرَف أيضاً باسم آكل البكتيريا. بينما يقول الباحثون إن فيروس كولني الجديد قد يكون "مُنقذاً للحياة". على أثر ذلك، قرَّرَ أعضاء اللجنة الدولية لتصنيف الفيروسات أن الفيروس الجديد متميِّز وراثياً بدرجةٍ كافية لتشكيل جنسٍ جديد من الفيروسات، وسمّوه باسم قرية كولني.
من جهتها، قالت الدكتورة إيفلين أدريانسنز، رئيسة اللجنة الفرعية للفيروسات البكتيرية في اللجنة الدولية لتصنيف الفيروسات: "نتطلَّع دائماً إلى تكريم الأشخاص أو الأماكن أو المعاهد المشارِكة في الوصف الأول لمجموعةٍ جديدة من الفيروسات"، مضيفة: "من المناسب تماماً تسمية الفيروس على اسم قرية كولني، حيث تُدرَس كثير من العلوم الممتازة". رغم أن عدد سكان قرية كولني لا يتجاوز 120 شخصاً، فإنها موطنٌ لعددٍ من المعاهد البحثية، علاوة على مستشفى نوفولك الجامعي.









